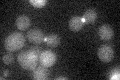

View description
Daughter cell-specific protein, may help establish daughter fate
Localization:
Intensity:
Fold change:
Significance:
-
C’ GFP library in SD
bud neckN/A -
N' NOP1pr-GFP in SD

cytosol,bud39.1996 -
N' TEF2pr-mCherry in SD

below threshold7.53424 -
N' NATIVEpr-GFP in SD

bud neck27.3089 -
N' TEF2pr-VC and Cyto-VN in SD

below threshold24.4856 -
C’ GFP library in SD+DTT

bud neck16.760.9No -
C’ GFP library in SD+H2O2

bud neck18.440.99No -
C’ GFP library in Starvation Media

cytosol14.270.77No -
C’ GFP library on the background of Pup2-DaMP

bud neck -
C’ GFP library on the background of CCT mutant

bud neck19.49221.05143No
